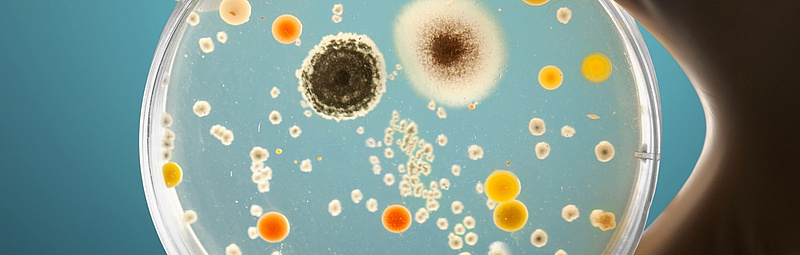
Eine Hand hält eine Petrischale, auf der eine Vielzahl unterschiedlicher Mikroorganismen wachsen

-
Die Universität
- Herzlich willkommen
- Das sind wir
- Medien & PR
-
Studium
- Allgemein
- Studienangebot
- Campusleben
-
Forschung
- Profil
- Infrastruktur
- Kooperationen
- Services
-
Karriere
- Arbeitgeberin Med Uni Graz
- Potenziale
- Arbeitsumfeld
- Offene Stellen
-
Diagnostik
- Patient*innen
- Zuweiser*innen
- Gesundheitsthemen
- Gesundheitsinfrastruktur